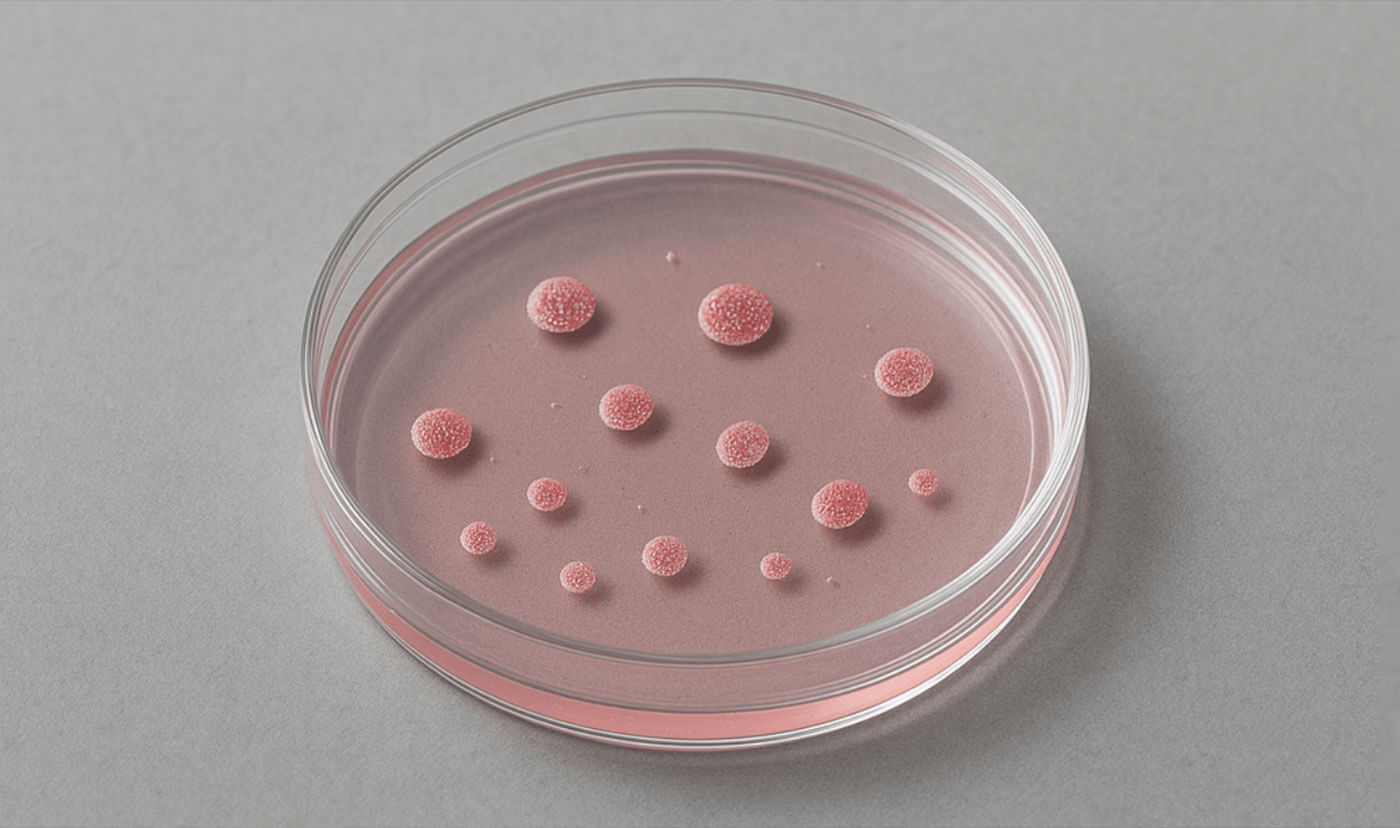
Patient-derived organoids

The AI reality check
Owkin is the only agentic AI company co-founded and led by a medical oncologist. That guidance keeps patient impact front and centre of our mission. We want to bring better treatments to the clinic, faster.




For patients, always
Too many AI models never impact patients, because their predictions don’t work in the real world. That’s why we continuously test our models in real patient populations, so they are always learning from real patient responses and improving.
Patient Validation Hub

Start with patient data
The foundation of all our models is patient data. This keeps their initial predictions closer to the ground truth of biology and allows them to see patterns and activity that simpler systems miss.
That’s why our philosophy is always: from real-world patient data to real-world impact.


We work with our sister company, Waiv (formerly Owkin Dx), to bring AI models into diagnostic practice. Waiv has multiple AI products in the clinic, including RlapsRisk BC and the MSIntuit Suite, and co-development programs with MSD and AstraZeneca.
The AI behind these models was originally developed by Owkin, and has been through rigorous patient testing, earning the products high-level regulatory approval through CE-marking.


Clinical trials are the true test for any AI-proposed treatment. We run INVOKE - the clinical trial for our AI-enabled asset OKN4395 - testing the accuracy of our AI’s predictions in real world patients.
The trial regularly produces patient data which we continuously integrate into our ongoing AI training, to keep our AI based on real-world, up-to-date patient responses.
Lab-in-the-loop
Before clinical trials, new treatments must be tested in model laboratory systems. Owkin’s lab-in-the-loop specializes in a state-of-the-art model system: patient-derived organoids.
These are mini versions of human organs, grown in petri dishes from patient cells. They match what’s happening in the human body more closely than other lab model systems, so the results are more likely to be accurate.
Owkin's AI Scientist
We're building thousands of AI scientists that work 24/7 to accelerate medical breakthroughs, to compress decades of discovery into years.
The AI agent for biology, powered by multimodal patient data, for smarter biopharma decision making.
